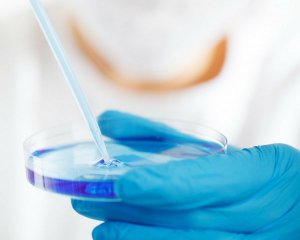

В общем китайская вакцина CoronaVac, которую закупила Украина, эффективна на 78%.
Ученые Института Бутантата считают, что ее защита составляет 50,4% в легких случаях без госпитализации, пишет Reuters.
На прошлой неделе исследования препарата в Бразилии показали его эффективность на уровне 78% в тяжелых и легких случаях. Но они ничего не указали о действии вакцины в очень легких случаях, когда людям не нужна клиническая помощь.
ЧИТАЙТЕ ТАКЖЕ: Назвали безопасные для Украины вакцины
По словам медицинского директора клинических исследований в Институте Бутантата Рикардо Паласиоса, вакцина показала 100% защиту в тяжелых случаях заболевания. Меньше она защищает группу людей с очень легкими случаями, в которой было 167 добровольцев из 12 476. Ни одного из добровольцев после введения вакцины не госпитализировали с коронавирусом.
"Мы предполагали, что вакцина будет менее эффективной в легких случаях и более результативной в тяжелых случаях. Мы смогли продемонстрировать это. Это эффективная вакцина", - сказали в институте.
Перед заказом препарата CoronaVac китайской компании Sinovac Biotech Минздрав хочет получить конечные выводы исследований по эффективности Covid-вакцины непосредственно от производителя. В договоре Украина указала требование об эффективности препарата на уровне не менее чем 70%, заявил министр здравоохранения Максим Степанов.
Комментарии